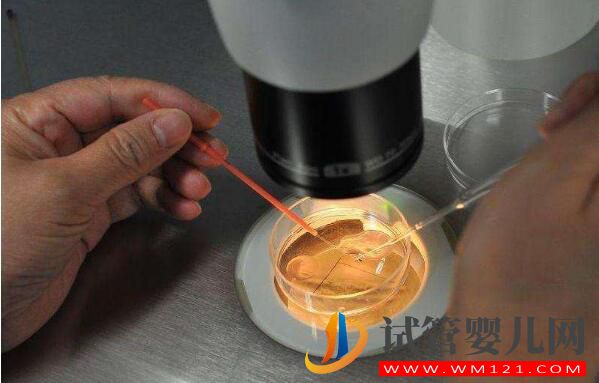
做試管嬰兒取多少個(gè)卵子合適？(圖2)

做試管嬰兒取多少個(gè)卵子合適?
在試管嬰兒過(guò)程中,準(zhǔn)媽媽害怕的一個(gè)環(huán)節(jié)就是促排卵,取卵也是試管過(guò)程中非常重要的一環(huán),為了取到好卵,準(zhǔn)媽媽們都經(jīng)歷了漫長(zhǎng)的促排卵打針吃藥階段,但是到取卵的時(shí)候,準(zhǔn)媽媽們會(huì)發(fā)現(xiàn),有些人可以一次性很多顆卵子,但是有些只能取到幾顆,但是獲卵數(shù)越多的女性,卵巢出現(xiàn)過(guò)激反應(yīng)的幾率越大,因此監(jiān)測(cè)卵泡發(fā)育的時(shí)候要注意預(yù)防過(guò)激,那么到底做試管嬰兒要取多少顆卵子才適合呢?

做試管嬰兒要取多少個(gè)卵子?
試管嬰兒并沒(méi)有規(guī)定說(shuō)一定要取到多少個(gè)卵子才是合適的說(shuō)法。一般一般獲卵8-15個(gè)較為合適。
根據(jù)每個(gè)女性的年齡、卵巢功能、周期方案、藥物反應(yīng)等情況的不同,獲卵數(shù)肯定會(huì)有一定差異。
卵泡的數(shù)量并不能卵子的質(zhì)量,對(duì)于做試管嬰兒來(lái)說(shuō),卵子質(zhì)量是要大于取卵數(shù)量。取到卵子的多少并不是試管嬰兒成功率的,只是說(shuō)取到的卵子越多,后期培養(yǎng)成胚胎的數(shù)量就會(huì)更多,可以嘗試的機(jī)會(huì)也就越多。
試管嬰兒取多少個(gè)卵才夠用?
理論上來(lái)說(shuō),取卵數(shù)量越多越好。但過(guò)度的卵巢刺激可能會(huì)影響卵子質(zhì)量,也會(huì)對(duì)女性身體造成傷害,所以取卵數(shù)量有一個(gè)較理想的范圍。
1、比較年輕,卵巢功能良好的女性,理想的獲卵數(shù)在8-12個(gè)左右,就可以達(dá)到60%-70%以上的妊娠率。
2、高齡或卵巢功能不好的女性,目標(biāo)獲卵數(shù)在2-5枚,這種情況下妊娠率就會(huì)比較低,因此可能會(huì)經(jīng)歷多次取卵,以增加妊娠率。
3、雖然說(shuō)卵子數(shù)量很重要,但質(zhì)量更重要。所以對(duì)做試管嬰兒的女性而言,同時(shí)也要注意提高卵子的質(zhì)量,有時(shí)候有一個(gè)優(yōu)質(zhì)的卵子,也可以較終成功受孕的。有些女性取卵很多,較終卻連一個(gè)優(yōu)質(zhì)胚胎都配不出來(lái),就是因?yàn)槁炎淤|(zhì)量差。
女性在取卵后無(wú)需進(jìn)行比較,因?yàn)槁炎訑?shù)量并不代表較終結(jié)果。從始基卵泡發(fā)育到成熟卵泡,平均需要85天,正所謂“用卵一日,養(yǎng)卵三月”,提前3個(gè)月調(diào)理身體,提高卵子質(zhì)量才是真理。

影響取卵數(shù)目的因素
1、FSH(促卵泡激素):月經(jīng)第2-3天血液檢測(cè)測(cè)量FSH值。醫(yī)生會(huì)根據(jù)FSH值來(lái)判斷卵巢對(duì)促排卵藥物的反應(yīng)程度。
2、AFC(竇卵泡個(gè)數(shù)):月經(jīng)第2-3天B超看到的基礎(chǔ)竇卵泡個(gè)數(shù)和卵巢體積是判斷卵巢儲(chǔ)備的重要指標(biāo)。。
3、AMH(抗穆勒試管激素):AMH由竇前卵泡和小竇卵泡的顆粒細(xì)胞分泌,是一種用來(lái)體現(xiàn)卵巢在促排卵過(guò)程中反應(yīng)性的標(biāo)志物。一般根據(jù)這個(gè)數(shù)值來(lái)判斷患者的卵巢功能情況。
試管嬰兒取卵如何取出高質(zhì)量的卵子?
從始基卵泡發(fā)育到卵泡成熟的時(shí)間平均需要85天,正所謂“用卵一日,養(yǎng)卵三月”,而臨床上很多女性在試管嬰兒過(guò)程中,只注重了促排卵,卻忽視了養(yǎng)卵。影響卵子質(zhì)量的因素,除了年齡外,生活方式的影響是較大的,健康飲食、適當(dāng)運(yùn)動(dòng)、規(guī)律睡眠,并保持樂(lè)觀開(kāi)朗的心態(tài),都有助于提高卵子質(zhì)量。建議做試管嬰兒的患者,在進(jìn)周前就開(kāi)始做好養(yǎng)卵準(zhǔn)備,以養(yǎng)出好卵子,為試管嬰兒的成功打下基礎(chǔ)。

取卵是怎么操作的
較常用的取卵方式是在的局部麻醉下,經(jīng)陰道B超引導(dǎo)下,將取卵針穿過(guò)陰道穹窿,直達(dá)卵巢,穿刺卵巢內(nèi)的卵泡,負(fù)壓吸出卵泡液以及其中的卵子。
通常醫(yī)生會(huì)關(guān)上燈操作,以便于B超屏幕顯示得更清楚,您只要按要求躺著就好,身體不要?jiǎng)印?/div>
這里說(shuō)明一下,雖然取卵是個(gè)小手術(shù),但是還是會(huì)對(duì)卵巢有一定傷害的,所以,一定要去正規(guī)醫(yī)院進(jìn)行手術(shù)!更要做好后期的保養(yǎng)問(wèn)題。
人工取卵手術(shù)用的取卵針大概有35cm長(zhǎng)、2mm粗,這么一根又長(zhǎng)又粗的取卵針是要進(jìn)入卵巢的卵泡里面的,如果取20個(gè)卵,那卵巢有可能會(huì)造成8-10個(gè)傷口。
對(duì)于卵巢儲(chǔ)備不足的患者,要及時(shí)盡早,抓緊時(shí)間利用好每一顆卵子;并且在平時(shí)的生活中也要注意飲食作息等,調(diào)節(jié)自身內(nèi)分泌水平,提升卵子的質(zhì)量,只有健康的卵子跟精子結(jié)合,才能發(fā)育成優(yōu)質(zhì)胚胎,試管嬰兒成功率才會(huì)更高。
本文標(biāo)題:做試管嬰兒取多少個(gè)卵子合適?
本文鏈接:http://www.sdxbf.com/news/921.html
上一篇:試管的流程,大概流程詳細(xì)流程 下一篇:從試管流程看“試管寶寶9成不是自己親生的”這一偽命題





